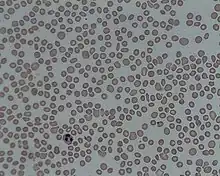

Thrombocytopenia
| Thrombocytopenia | |
|---|---|
| Other names | Thrombocytopaenia, thrombopenia |
| |
| A photomicrograph of the blood showing thrombocytopenia | |
| Specialty | Hematology |
| Causes | Bone marrow not making enough platelets, body destroying platelets, spleen holding too many platelets[1] |
| Diagnostic method | Complete blood count[1] |
| Treatment | None, immunosuppressants, platelet transfusion, surgical removal of the spleen[1] |
In hematology, thrombocytopenia is a condition characterized by abnormally low levels of platelets (also known as thrombocytes) in the blood.[2] Low levels of platelets in turn may lead to prolonged or excessive bleeding. It is the most common coagulation disorder among intensive care patients and is seen in a fifth of medical patients and a third of surgical patients.[3]
A normal human platelet count ranges from 150,000 to 450,000 platelets/microliter (μL) of blood.[4] Values outside this range do not necessarily indicate disease. One common definition of thrombocytopenia requiring emergency treatment is a platelet count below 50,000/μL.[5] Thrombocytopenia can be contrasted with the conditions associated with an abnormally high level of platelets in the blood – thrombocythemia (when the cause is unknown), and thrombocytosis (when the cause is known).[6][7]
Signs and symptoms

Thrombocytopenia usually has no symptoms and is picked up on a routine complete blood count. Some individuals with thrombocytopenia may experience external bleeding, such as nosebleeds or bleeding gums. Some women may have heavier or longer periods or breakthrough bleeding. Bruising, particularly purpura in the forearms and petechiae in the feet, legs, and mucous membranes, may be caused by spontaneous bleeding under the skin.[8][9]
Eliciting a full medical history is vital to ensure the low platelet count is not secondary to another disorder. Ensuring that the other blood cell types, such as red blood cells and white blood cells, are not also suppressed, is also important.[8] Painless, round, and pinpoint (1 to 3 mm in diameter) petechiae usually appear and fade, and sometimes group to form ecchymoses. Larger than petechiae, ecchymoses are purple, blue, or yellow-green areas of skin that vary in size and shape. They can occur anywhere on the body.[8]
A person with this disease may also complain of malaise, fatigue, and general weakness (with or without accompanying blood loss). Acquired thrombocytopenia may be associated with the use of certain drugs. Inspection typically reveals evidence of bleeding (petechiae or ecchymoses), along with slow, continuous bleeding from any injuries or wounds. Adults may have large, blood-filled bullae in the mouth.[10] If the person's platelet count is between 30,000 and 50,000/μL, bruising with minor trauma may be expected; if it is between 15,000 and 30,000/μL, spontaneous bruising will be seen (mostly on the arms and legs).[11]
Causes
Thrombocytopenia can be inherited or acquired.[12]
Decreased production
Abnormally low platelet production may be caused by:[13]
- Dehydration, vitamin B12 or folic acid deficiency
- Leukemia, myelodysplastic syndrome, or aplastic anemia
- Decreased production of thrombopoietin by the liver in liver failure
- Sepsis, systemic viral or bacterial infection
- Leptospirosis
- Hereditary syndromes[14]
- ACTN1-related thrombocytopenia
- Amegakaryocytic thrombocytopenia with radio-ulnar synostosis
- ANKRD26 related thrombocytopenia
- Autosomal dominant thrombocytopenia
- Bernard–Soulier syndrome (associated with giant platelet disorder)
- Congenital amegakaryocytic thrombocytopenia
- Congenital amegakaryocytic thrombocytopenia and radioulnar synostosis
- CYCS-related thrombocytopenia
- Epstein syndrome (associated with giant platelet disorder)
- ETV6 related thrombocytopenia
- Fanconi anemia
- Filaminopathies A
- FYB related thrombocytopenia
- Glanzmann's thrombasthenia
- GNE myopathy with congenital thrombocytopenia
- Gray platelet syndrome (associated with giant platelet disorder)
- Harris platelet syndrome (associated with giant platelet disorder)
- Macrothrombocytopenia and hearing loss
- May–Hegglin anomaly (associated with giant platelet disorder)
- MYH9-related disease (associated with giant platelet disorder)
- PRKACG-related thrombocytopenia
- Paris-Trousseau thrombocytopenia/Jacobsen syndrome
- Sebastian syndrome
- SLFN14-related thrombocytopenia
- Stormorken syndrome
- TRPM7-related thrombocytopenia
- Thrombocytopenia absent radius syndrome
- Tropomyosin 4-related thrombocytopenia
- TUBB1-related thrombocytopenia
- Upshaw–Schulman syndrome
- Wiskott–Aldrich syndrome
- X-linked thrombocytopenia
- X-linked thrombocytopenia with thalassemia
Increased destruction

Abnormally high rates of platelet destruction may be due to immune or nonimmune conditions, including:[15]
- Immune thrombocytopenic purpura
- Thrombotic thrombocytopenic purpura
- Hemolytic–uremic syndrome
- Disseminated intravascular coagulation
- Paroxysmal nocturnal hemoglobinuria
- Antiphospholipid syndrome
- Systemic lupus erythematosus
- Post-transfusion purpura
- Neonatal alloimmune thrombocytopenia
- Hypersplenism
- Dengue fever
- Gaucher's disease
- Zika virus
Medication-induced
These medications can induce thrombocytopenia through direct myelosuppression:[16]
Other causes
- Laboratory error, possibly due to the anticoagulant EDTA in CBC specimen tubes; a citrated platelet count is a useful follow-up study[17]
- Snakebite[18]
- Lyme disease[19]
- Thrombocytapheresis (also called plateletpheresis)
- Niemann–Pick disease[20][21]
Diagnosis
Laboratory tests for thrombocytopenia might include full blood count, liver enzymes, kidney function, vitamin B12 levels, folic acid levels, erythrocyte sedimentation rate, and peripheral blood smear. If the cause for the low platelet count remains unclear, a bone marrow biopsy is usually recommended to differentiate cases of decreased platelet production from cases of peripheral platelet destruction.[22]
Thrombocytopenia in hospitalized alcoholics may be caused by spleen enlargement, folate deficiency, and most frequently, the direct toxic effect of alcohol on production, survival time, and function of platelets.[23] Platelet count begins to rise after 2 to 5 days' abstinence from alcohol. The condition is generally benign, and clinically significant hemorrhage is rare.
In severe thrombocytopenia, a bone marrow study can determine the number, size, and maturity of the megakaryocytes. This information may identify ineffective platelet production as the cause of thrombocytopenia and rule out a malignant disease process at the same time.[24]
Treatment
Treatment is guided by the severity and specific cause of the disease. Treatment focuses on eliminating the underlying problem, whether that means discontinuing drugs suspected to cause it or treating underlying sepsis. Diagnosis and treatment of serious thrombocytopenia is usually directed by a hematologist. Corticosteroids may be used to increase platelet production. Lithium carbonate or folate may also be used to stimulate platelet production in the bone marrow.[25]
Platelet transfusions
Platelet transfusions may be suggested for people who have a low platelet count due to thrombocytopenia.[26]
Thrombotic thrombocytopenic purpura
Treatment of thrombotic thrombocytopenic purpura (TTP) is a medical emergency, since the associated hemolytic anemia and platelet activation can lead to kidney failure and changes in the level of consciousness. Treatment of TTP was revolutionized in the 1980s with the application of plasmapheresis. According to the Furlan–Tsai hypothesis,[27] this treatment works by removing antibodies against the von Willebrand factor-cleaving protease ADAMTS-13. The plasmapheresis procedure also adds active ADAMTS-13 protease proteins to the patient, restoring a normal level of von Willebrand factor multimers. Patients with persistent antibodies against ADAMTS-13 do not always manifest TTP, and these antibodies alone are not sufficient to explain how plasmapheresis treats TTP.[28]
Immune thrombocytopenic purpura
Many cases of immune thrombocytopenic purpura (ITP), also known as idiopathic thrombocytopenic purpura, can be left untreated, and spontaneous remission (especially in children) is not uncommon. However, counts under 50,000/μL are usually monitored with regular blood tests, and those with counts under 10,000/μL are usually treated, as the risk of serious spontaneous bleeding is high with such low platelet counts. Any patient experiencing severe bleeding symptoms is also usually treated. The threshold for treating ITP has decreased since the 1990s; hematologists recognize that patients rarely spontaneously bleed with platelet counts greater than 10,000/μL, although exceptions to this observation have been documented.[29][30]
Thrombopoetin analogues have been tested extensively for the treatment of ITP. These agents had previously shown promise, but had been found to stimulate antibodies against endogenous thrombopoietin or lead to thrombosis. Romiplostim (trade name Nplate, formerly AMG 531) was found to be safe and effective for the treatment of ITP in refractory patients, especially those who relapsed following splenectomy.[31]
Heparin-induced thrombocytopenia
Discontinuation of heparin is critical in a case of heparin-induced thrombocytopenia (HIT). Beyond that, however, clinicians generally treat to avoid thrombosis.[32] Treatment may include a direct thrombin inhibitor, such as lepirudin or argatroban. Other "blood thinners" sometimes used in this setting include bivalirudin and fondaparinux. Platelet transfusions are not routinely used to treat HIT because thrombosis, not bleeding, is the primary problem.[33] Warfarin is not recommended until platelets have normalized.[33]
Congenital amegakaryocytic thrombocytopenia
Bone marrow/stem cell transplants are the only known cures for this genetic disease. Frequent platelet transfusions are required to keep the patient from bleeding to death before the transplant can be performed, although this is not always the case.[34]
Human-induced pluripotent stem cell-derived platelets
Human-induced pluripotent stem cell-derived platelets is a technology currently being researched by the private sector, in association with the Biomedical Advanced Research and Development Authority and the U.S. Department of Health and Human Services, that would create platelets outside the human body.[35]
Neonatal thrombocytopenia
Thrombocytopenia affects a few newborns, and its prevalence in neonatal intensive care units is high. Normally, it is mild and resolves without consequences. Most cases affect preterm birth infants and result from placental insufficiency and/or fetal hypoxia. Other causes, such as alloimmunity, genetics, autoimmunity, and infection, are less frequent.[36]
Thrombocytopenia that starts after the first 72 hours, since birth is often the result of underlying sepsis or necrotizing enterocolitis.[36] In the case of infection, polymerase chain reaction tests may be useful for rapid pathogen identification and detection of antibiotic-resistance genes. Possible pathogens include viruses (e.g. cytomegalovirus,[36] rubella virus,[36] HIV[36]), bacteria (e.g. Staphylococcus spp.,[37] Enterococcus spp.,[37] Streptococcus agalactiae,[36] Listeria monocytogenes,[36] Escherichia coli,[36][37] Haemophilus influenzae,[36] Klebsiella pneumoniae,[37] Pseudomonas aeruginosa,[37][38] Yersinia enterocolitica[38]), fungi (e.g. Candida spp.[37]), and Toxoplasma gondii.[36] The severity of thrombocytopenia may be correlated with pathogen type; some research indicates that the most severe cases are related to fungal or Gram-negative bacterial infection.[37] The pathogen may be transmitted during[39] or before birth, by breast feeding,[40][41][42] or during transfusion.[43] Interleukin-11 is being investigated as a drug for managing thrombocytopenia, especially in cases of sepsis or necrotizing enterocolitis.[36]
References
- 1 2 3 "Thrombocytopenia". National Heart, Lung, and Blood Institute (NHLBI). U.S. Department of Health and Human Services. Archived from the original on 25 November 2020. Retrieved 4 January 2018.
- ↑ Deutschman CS, Neligan PJ (2010). Evidence-based Practice of Critical Care. Elsevier Health Sciences. ISBN 978-1416054764. Archived from the original on 2023-01-11. Retrieved 2015-04-30.
- ↑ Marini JJ, Dries DJ (2019). Critical care medicine: the essentials and more. Philadelphia: Wolters Kluwer. ISBN 978-1-4963-0291-5. OCLC 1060947164.
- ↑ "Platelet count". MedlinePlus Medical Encyclopedia. U.S. National Library of Medicine. Archived from the original on 2015-04-05. Retrieved 2015-05-01.
- ↑ "What Is Thrombocytopenia?". National Heart, Lung, and Blood Institute (NHLBI). U.S. Department of Health and Human Services. Archived from the original on 2015-05-18. Retrieved 2015-05-01.
- ↑ Schafer AI (March 2004). "Thrombocytosis". The New England Journal of Medicine. 350 (12): 1211–1219. doi:10.1056/NEJMra035363. PMID 15028825.
- ↑ "Thrombocythemia and Thrombocytosis". National Heart, Lung, and Blood Institute (NHLBI). U.S. Department of Health and Human Services. Archived from the original on 14 June 2019. Retrieved 5 August 2020.
- 1 2 3 Bhatia MP. "B.E. Project on Platlet Count Using Image Processing Techniques" (PDF). BTP_Report. Archived (PDF) from the original on 10 September 2016. Retrieved 30 November 2014.
- ↑ Houghton AR, Gray D (2010). Chamberlain's Symptoms and Signs in Clinical Medicine 13th Edition, An Introduction to Medical Diagnosis. CRC Press. ISBN 9780340974254. Archived from the original on 2023-01-11. Retrieved 2015-05-01.
- ↑ Interpreting Signs and Symptoms. Lippincott Williams & Wilkins. 2007. p. 293. ISBN 9781582556680.
- ↑ Rosdahl CB, Kowalski MT (2008). Textbook of Basic Nursing. Lippincott Williams & Wilkins. ISBN 9780781765213. Archived from the original on 2023-01-11. Retrieved 2015-05-01.
- ↑ "What Causes Thrombocytopenia?". National Heart, Lung, and Blood Institute (NHLBI). U.S. Department of Health and Human Services. Archived from the original on 2 December 2014. Retrieved 4 December 2014.
- ↑ Fiebach NH, Barker LR, Burton JR, Zieve PD (2007). Principles of Ambulatory Medicine. Lippincott Williams & Wilkins. ISBN 9780781762274. Retrieved 2015-04-30.
- ↑ Almazni I, Stapley R, Morgan NV (2019) Inherited Thrombocytopenia: Update on genes and genetic variants which may be associated With bleeding. Front Cardiovasc Med
- ↑ Rodak BF, Fritsma GA, Keohane E (2013). Hematology: Clinical Principles and Applications. Elsevier Health Sciences. ISBN 9780323292696. Archived from the original on 2023-01-11. Retrieved 2015-04-30.
- ↑ Gresele P, Fuster V, Lopez JA, Page CP, Vermylen J (2007). Platelets in Hematologic and Cardiovascular Disorders: A Clinical Handbook. Cambridge University Press. ISBN 9781139468763. Retrieved 2015-04-30.
- ↑ Tan GC, Stalling M, Dennis G, Nunez M, Kahwash SB (2016). "Pseudothrombocytopenia due to Platelet Clumping: A Case Report and Brief Review of the Literature". Case Reports in Hematology. 2016: 3036476. doi:10.1155/2016/3036476. PMC 5164902. PMID 28044112.
- ↑ Waldmann C, Soni N, Rhodes A (2008). Oxford Desk Reference: Critical Care. Oxford University Press. ISBN 9780199229581. Archived from the original on 2023-01-11. Retrieved 2015-05-01.
- ↑ Greer JP, Arber DA, Glader B, List AF, Means RT, Paraskevas F, Rodgers GM (2013). Wintrobe's Clinical Hematology. Lippincott Williams & Wilkins. ISBN 9781469846224. Archived from the original on 2023-01-11. Retrieved 2015-05-01.
- ↑ "Niemann-Pick disease". Genetics Home Reference. U.S. National Library of Medicine. Archived from the original on 2018-09-24. Retrieved 2020-06-12.
- ↑ "Niemann-Pick - Symptoms and causes". Mayo Clinic. Archived from the original on 2020-08-04. Retrieved 2020-06-12.
- ↑ "How Is Thrombocytopenia Diagnosed?". National Heart, Lung, and Blood Institute (NHLBI). U.S. Department of Health and Human Services. Archived from the original on 2015-05-25. Retrieved 2015-05-19.
- ↑ Lieber CS (2012). Medical and Nutritional Complications of Alcoholism: Mechanisms and Management. Springer Science & Business Media. ISBN 9781461533207. Archived from the original on 2023-01-11. Retrieved 2020-10-10.
- ↑ Hillyer CD, Abrams CS, Shaz BH, Roshal M, Zimring JC, Abshire TC (2009). Transfusion Medicine and Hemostasis: Clinical and Laboratory Aspects. Elsevier. ISBN 9780080922300. Retrieved 2015-05-01.
- ↑ Lawrence PF, Bell RM, Dayton MT (2012-10-31). Essentials of General Surgery. Lippincott Williams & Wilkins. ISBN 9780781784955. Archived from the original on 2023-01-11. Retrieved 2020-10-10.
- ↑ Estcourt LJ, Malouf R, Hopewell S, Doree C, Van Veen J, et al. (Cochrane Haematological Malignancies Group) (April 2018). "Use of platelet transfusions prior to lumbar punctures or epidural anaesthesia for the prevention of complications in people with thrombocytopenia". The Cochrane Database of Systematic Reviews. 2018 (4): CD011980. doi:10.1002/14651858.CD011980.pub3. PMC 5957267. PMID 29709077.
- ↑ Chapman K, Seldon M, Richards R (February 2012). "Thrombotic microangiopathies, thrombotic thrombocytopenic purpura, and ADAMTS-13". Seminars in Thrombosis and Hemostasis. 38 (1): 47–54. doi:10.1055/s-0031-1300951. PMID 22314603.
- ↑ "How Is Thrombotic Thrombocytopenic Purpura Treated?". National Heart, Lung, and Blood Institute (NHLBI). U.S. Department of Health and Human Services. Archived from the original on 2015-05-01. Retrieved 2015-05-20.
- ↑ Thrombocytopenic Purpura: New Insights for the Healthcare Professional: 2013 Edition: ScholarlyPaper. ScholarlyEditions. 2013-07-22. ISBN 9781481662420. Archived from the original on 2023-01-11. Retrieved 2015-05-20.
- ↑ "Idiopathic thrombocytopenic purpura (ITP)". MedlinePlus Medical Encyclopedia. U.S. National Library of Medicine. Archived from the original on 2015-04-06. Retrieved 2015-05-20.
- ↑ "Nplate (romiplostim) for subcutaneous injection". www.fda.gov. Archived from the original on 2016-03-11. Retrieved 2015-05-02.
- ↑ Warkentin TE, Greinacher A (2007-07-23). Heparin-Induced Thrombocytopenia. CRC Press. ISBN 9781439826423. Archived from the original on 2023-01-11. Retrieved 2023-08-25.
- 1 2 Ahmed I, Majeed A, Powell R (September 2007). "Heparin induced thrombocytopenia: diagnosis and management update". Postgraduate Medical Journal. 83 (983): 575–582. doi:10.1136/pgmj.2007.059188. PMC 2600013. PMID 17823223.
- ↑ Smit-Sibinga CH (2010-05-10). Neonatology and Blood Transfusion. Springer Science & Business Media. ISBN 9780387236001. Archived from the original on 2023-01-11. Retrieved 2015-05-20.
- ↑ Clark D (2019-10-02). "New technology may aid emergency preparedness". Homeland Preparedness News. Archived from the original on 2019-10-05. Retrieved 2019-10-23.
- 1 2 3 4 5 6 7 8 9 10 11 Roberts I, Murray NA (September 2003). "Neonatal thrombocytopenia: causes and management". Archives of Disease in Childhood. Fetal and Neonatal Edition. 88 (5): F359 – F364. doi:10.1136/fn.88.5.F359. PMC 1721612. PMID 12937037.
- 1 2 3 4 5 6 7 Guida JD, Kunig AM, Leef KH, McKenzie SE, Paul DA (June 2003). "Platelet count and sepsis in very low birth weight neonates: is there an organism-specific response?". Pediatrics. 111 (6 Pt 1): 1411–1415. doi:10.1542/peds.111.6.1411. PMID 12777561.
- 1 2 Pacifico L, Chiesa C, Mirabella S, Panero A, Midulla M (March 1987). "Early-onset Pseudomonas aeruginosa sepsis and Yersinia enterocolitica neonatal infection: a unique combination in a preterm infant". European Journal of Pediatrics. 146 (2): 192–193. doi:10.1007/BF02343233. PMID 3569360. S2CID 20198866.
- ↑ Rempen A, Martius J, Hartmann AA, Wecker I (1987). "Transmission rate of Ureaplasma urealyticum, Mycoplasma spp., Gardnerella vaginalis, B-streptococci, Candida spp. and Chlamydia trachomatis from the mother to the newborn". Archives of Gynecology and Obstetrics. 241 (3): 165–170. doi:10.1007/BF00931313. PMID 3324978. S2CID 11251976.
- ↑ Olver WJ, Bond DW, Boswell TC, Watkin SL (July 2000). "Neonatal group B streptococcal disease associated with infected breast milk". Archives of Disease in Childhood. Fetal and Neonatal Edition. 83 (1): F48 – F49. doi:10.1136/fn.83.1.F48. PMC 1721104. PMID 10873172.
- ↑ Kotiw M, Zhang GW, Daggard G, Reiss-Levy E, Tapsall JW, Numa A (2003). "Late-onset and recurrent neonatal Group B streptococcal disease associated with breast-milk transmission". Pediatric and Developmental Pathology. 6 (3): 251–256. doi:10.1007/s10024-001-0276-y. PMID 12687430. S2CID 20696142.
- ↑ Gastelum DT, Dassey D, Mascola L, Yasuda LM (December 2005). "Transmission of community-associated methicillin-resistant Staphylococcus aureus from breast milk in the neonatal intensive care unit". The Pediatric Infectious Disease Journal. 24 (12): 1122–1124. doi:10.1097/01.inf.0000189983.71585.30. PMID 16371885.
- ↑ Jagielski M, Rastawicki W, Kałuzewski S, Gierczyński R (2007). "[Yersiniosis--unappreciated infectious disease]" [Yersiniosis – unappreciated infectious diseases] (PDF). Przeglad Epidemiologiczny (in Polish). 56 (1): 57–64. PMID 12150068. Archived from the original (PDF) on 2011-10-03. Retrieved 2011-04-10.